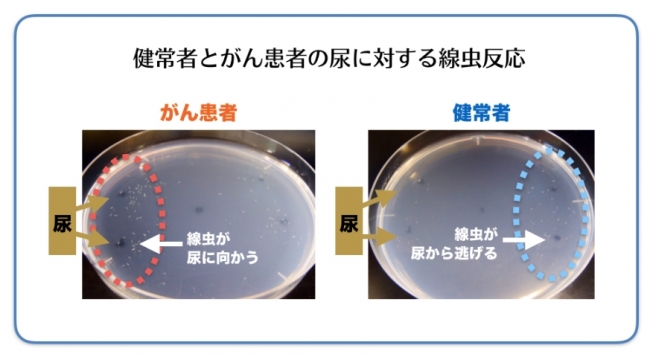
早期がんを判別する「線虫」を用いた最新臨床研究の中間結果ご報告

T*️様 【お値下げ】N-NOSE 線虫ガン検査 HIROTSU BIO SCI 楽天市場】【ふるさと納税】 がん検査 キット エヌノーズ 4人分 セット
(4012件)
Pontaパス特典
サンキュー配送
6525円(税込)
66ポイント(1%)
Pontaパス会員ならさらに+1%ポイント還元!
送料
(
)
4690
配送情報
お届け予定日:2026.03.26 12:0までにお届け
※一部地域・離島につきましては、表示のお届け予定日期間内にお届けできない場合があります。
ロットナンバー
76530286530
お買い物の前にチェック!

Pontaパス会員なら
ポイント+1%
ポイント+1%
商品説明


ご覧いただきありがとうございます。未開封です。2025年の3月に届きました。2枚目の写真をご覧ください私宛の宛名の部分を剥がしたのですが、あまりきれいに剥がせておらずごめんなさい。検体提出は1ヵ月以内を推奨していますと書いてありますが、1ヵ月以上経ってももちろん問題なく検査ができる事は販売元に確認済みです。
| カテゴリー: | ダイエット・健康>>>健康管理・計測計>>>その他 |
|---|---|
| 商品の状態: | 新品、未使用","新品で購入し、一度も使用していない |
| 配送料の負担: | 送料込み(出品者負担) |
| 配送の方法: | 佐川急便/日本郵便 |
| 発送元の地域: | 東京都 |
| 発送までの日数: | 1~2日で発送 |
レビュー
商品の評価:




 4.8点(4012件)
4.8点(4012件)
- クルリンパ2015
- 小分けされていて1パック1人分で量も最適です。 半解凍ぐらいが食べ頃です。
- kika6818
- 良かったです。皆、満足しています。次回も頼みたいと思います。
- かおにゃい
- お歳暮時期なのに到着も早かったです。 馬刺しも大変柔らくて美味しかったです。 またリピしたいと思います。
- なつまるまる
- 敬老の日のギフトに購入しました。喜ばれたので、リピートします!
- こやちゃん2006
- 今日届き、さっそくいただきました。 とてもおいしかったです。
- hijiki123
- 美味しかった✨ しかも値段安い✨ まつ買いたいです🎶
- ヒメドリオジィ
- 昔、熊本に住んでいた頃を思い出しながら毎日食べても美味しい
- ちーちゃん7544
- 注文して素早く届きました。 年末の贅沢にプラス
- ちゃぴちゃっぴー6180
- プラス ワンコインで購入出来るので良かったです🎵
- FLEMING
- 普段は馬刺しといえば赤身でしたが、今回は三枚を選びました。 特に子供が気に入っていました。 昔から馬刺しを食べてきた実家の家族も、大変満足でした。
- HM33
- 自分用と職場の人に頼まれて購入しました。脂身が少なく美味しかったと、喜ばれました! また、リピします!
- dorasune02
- このお値段でしたら納得です。 たくさん食べたい人には良いチョイスだと思います。 部位は色々違うみたいですが。 ドリップはでますがそんなに臭みもなく ニンニク醤油がオススメだと思います。
すべて見る
お店の情報
7,367
連絡・応対
4.3
配送スピード
4.3
梱包
4.3